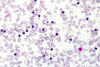

Heme1a Flashcards
What is anisocytosis?
Differences in size.
What is poikilocytosis?
Difference in shape.
What is MCV?
Mean Cell Volume. Normal is 80-100.
What is a Howell Jolly body?
The remnant of a nucleus. You see this in people without a spleen or a non-functioning spleen, like sickle cell pts.

What is Rouleaux formation?
RBCs that line up. It has to do with too much protein in the blood. Myeloma can be a cause.

What is the significance of tear drops? What is a common cause?
You see this when marrow is fibrotic and RBCs are being squeezed out. Tear drops are often found in B12 deficiency.

Pronormoblast.

The darker cell is the proerythroblast. The lighter cell is a myeloid cell. The myeloid cell on the right has more primary granules.
When are nucleated RBCs found in the peripheral blood?

Neonates.
What is this?

Nucleated RBCs in the peripheral blood.
When might you see this? What is it?

Basophilic stipling. You can see this is lead poisoning with coarse stipling. Fine basophilic stipling is seen when RBC production is increased in the marrow.
What are you seeing in this image?

Sideroblastic anemia. The blue dots are Fe deposits in the mitochonria. This is from a marrow aspiration.
How can you tell that these RBCs are too small?

Compare them to the size of the lymphocyte.
What are these, and when do you see them?

These are called Pappenheimer bodies, and they are sideroblasts in mature RBCs. Usually eliminated by the spleen, like Howell Jolly bodies.
What is this, and what are the hallmarks that you see?

This is megaloblastic anemia. I see macro-ovalocytes, Howell-Jolly bodies, hypersegmented neutrophil, anisocytosis and poikilocytosis.
What can cause this? What is it?

Megaloblastic anemia cause by B12 and folate deficiency.
What do you see? What is the mutation that causes this?

Hypochromatic RBCs, Howell-Jolly bodies, a sickel cell. There is a single GLU to VAL mutation.
What do you see? What is the underlying cause?
This is thalassemia. A genetic mutation causes a decrease in the rate of production of one of the globin chains.
What hemoglobins are increased in beta thalassemia?
Hgb A2 and F.
What test to you do to confirm this Dx? Is it increased or decreased? What is the Dx? What molecule is defective?

Ostmotic fragility test will be increased to confirm hereditary spherocytosis. Spectrin is the defective molecule in this disease.


